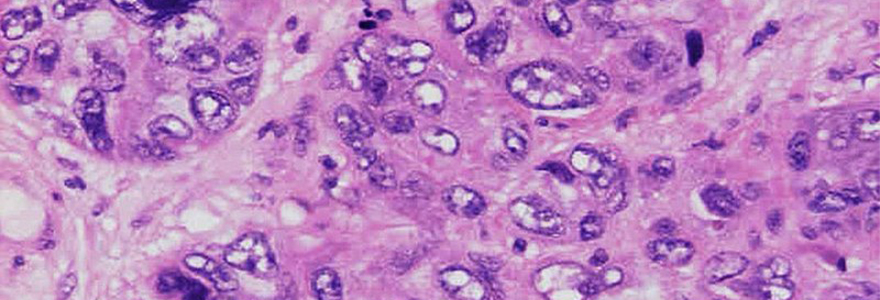

Seven interdisciplinary teams receive funding to solve research questions
By Communications
Schulich Medicine & Dentistry researchers are hoping to unlock some of the major health challenges of our day, thanks to funding from the School’s Collaborative Research Seed Grant (CRSG) program.
Seven new interdisciplinary teams received a share of approximately $375,000 in CRSG funding to build on different scientific and scholarly backgrounds that will facilitate breakthroughs in several research areas. The internal funding program – begun in 2013 – enables researchers to tackle these problems in a collaborative manner and positions them to successfully respond to requests for proposals from Tri-Council or other funding agencies.
Congratulations to the following recipients:
Project: Stress endotype of allergic disease
Allergic diseases typically begin in childhood and often occur with other inflammatory diseases as the individual ages. The severity of these diseases has been connected to increased stress, anxiety, and depression, and are associated with increased levels of the hormone cortisol. The team’s research suggests stress may play a role in the development of more serious conditions, such as asthma or rheumatoid arthritis. Identifying a stress endotype could help guide treatments.
Investigators:
- Lisa Cameron, PhD, Department of Pathology and Laboratory Medicine
- Samira Jeimy, MD, PhD, Department of Medicine - Division of Clinical Immunology and Allergy
- Rohit Lodhi, MD, PhD Department of Psychiatry - Division of General Adult Psychiatry
- Harold Kim, MD, Department of Obstetrics and Gynecology
Project: Tumor and systemic immune markers to measure breast cancer response to therapy
Breast cancer is one of the most common and deadliest cancers among women – particularly HER2-positive tumors and triple-negative tumors. Patients diagnosed with these high-risk tumors are often treated before surgery with chemotherapy and targeted immune therapies, but clinical benefit varies. This study will look at how some tumors escape detection by the patient’s immune system with the goal of predicting treatment response and identifying new drug targets to enable the development of new therapies.
Investigators:
- Vanessa Dumeaux, PhD, Department of Anatomy & Cell Biology
- Muriel Brackstone, MD, PhD, Department of Surgery - Division of General Surgery
- Armen Parsyan, MD, PhD, DSc, MPH Department of Surgery - Division of General Surgery
Project: Bone health and fracture prevention post stroke in Ontario
For more than 25,000 Ontarians who have a stroke each year, breaking a bone can be devastating and can lead to increased disability and reduced quality of life. The work will help identify who is at risk of breaking a bone after a stroke and how to best prevent it from happening.
Investigators:
- Jamie Fleet, MD, Department of Physical Medicine & Rehabilitation
- Kristin Clemens, MD, Department of Medicine - Division of Endocrinology and Metabolism
- Jenny Thain, MD, Department of Medicine - Division of Geriatric Medicine
- Tayyab Khan, MD, MPH, Department of Medicine - Division of Endocrinology and Metabolism
- Amit Garg, MD, PhD, Department of Medicine - Division of Nephrology
- Robert Teasell, MD, Department of Physical Medicine & Rehabilitation
Project: The experiences of accessing health-care services by people living with HIV in Southwestern Ontario: from service user perspective to curricular changes
Studies show that people living with HIV (PLHIV) can face barriers, including stigma and discrimination while accessing health-care services due to their ethnicity, gender identity, sexual orientation, living conditions or their Indigenous identity. This research will investigate whether HIV-positive individuals living in Southwestern Ontario face similar stigma while accessing health-care services and resources. It will also review the medicine and dentistry curricula at the Schulich School of Medicine & Dentistry to identify strengths, weaknesses and gaps related to PLHIV.
Investigators:
- Abbas Jessani, DDS, PhD, Schulich Dentistry
- Sarah McLean, PhD, Department of Anatomy & Cell Biology
- Charys Martin, PhD, Department of Anatomy & Cell Biology
- Michael Silverman, MD, Department of Infectious Diseases
Project: Identifying causes of neovaginal malodour in transfeminine people
Transfeminine individuals who have undergone vaginoplasty – the surgical creation of a vagina (called a neovagina) – often experience gynecological symptoms, the most common being malodour. The causes of neovaginal malodour remain unknown and current treatments are ineffective. Results from this study will guide future intervention studies treating neovaginal malodour and will contribute to evidence-based treatment guidelines for trans-specific health care.
Investigators:
- Jessica Prodger, PhD, Department of Microbiology & Immunology
- Debbie Penava, MD, MPH, Department of Obstetrics and Gynecology
Project: Epilepsy more than seizures: Multidisciplinary approach in comorbidities
Epilepsy is a common neurological disease that causes recurring seizures. Despite use of medications, one-third of patients continue to have seizures. Only a small percentage of these patients are candidates for epilepsy surgery. An alternative treatment is neuromodulation (electrical stimulation): including Vagus Nerve Stimulation and Deep-Brain Stimulation. This study will help identify patients who would benefit from neuromodulation therapy, with the goal of improving the quality of life of epilepsy patients and reducing epilepsy health-care costs, as well as better understanding sudden unexpected death in epilepsy (SUDEP).
Investigators:
- Ana Suller Marti, MD, PHD, Department of Clinical Neurological Sciences
- Alia Kashgari, MBBS, Department of Medicine - Division of Respirology
Project: Spatial proteogenomic landscape of breast cancer brain metastasis
Metastasis, which refers to the spread of cancer from the site of the primary tumor to other parts of the body, is a major cause of cancer-associated death. Breast cancer is the most common cancer among Canadian women (excluding non-melanoma skin cancers,) and brain metastasis occurs frequently in breast cancer. This project will employ cutting-edge proteomics and genomics tools to characterize breast cancer specimens in comparison to the brain metastasis to understand the systems and molecular basis of breast cancer brain metastasis. This study will also position researchers at the forefront of the burgeoning field of spatial proteogenomics and generate preliminary data that will support future external funding endeavours.
Investigators:
- Qi Zhang, MBBS, PhD, Department of Pathology & Laboratory Medicine
- Shawn Li, PhD, Department of Biochemistry
